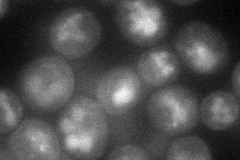
YHL040C

View description
Transporter, member of the ARN family of transporters that specifically recognize siderophore-iron chelates; responsible for uptake of iron bound to ferrirubin, ferrirhodin, and related siderophores
Localization:
Intensity:
Fold change:
Significance:
-
C’ GFP library in SD

below threshold15.27 -
N' NOP1pr-GFP in SD
cell periphery,vacuole57.5364 -
N' TEF2pr-mCherry in SD

missing0 -
N' NATIVEpr-GFP in SD

below threshold0 -
N' TEF2pr-VC and Cyto-VN in SD

cytosol31.491 -
C’ GFP library in SD+DTT

cytosol14.530.95No -
C’ GFP library in SD+H2O2

cytosol15.321No -
C’ GFP library in Starvation Media

cytosol15.681.02No -
C’ GFP library on the background of Pup2-DaMP

below threshold -
C’ GFP library on the background of CCT mutant

below threshold15.04750.984947No
